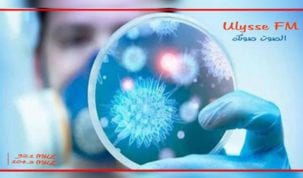

التصنيف: جهوية

المشيشي من بن قردان :07 مارس يوم تاريخي في تونس ولكل أحرار العالم
بمناسبة احياء الذكرى الخامسة لملحمة بنقردان التى تمكنت خلالها قوات الجيش والحرس والامن مسنودة باهالي بنقردان، من الاطاحة بمخطط

حالة احتقان في جربة ورئيس الحكومة يوضح ويطلب اجتماعا مع منظمات الجزيرة
احتشد عدد من نشطاء المجتمع المدني بجربة في وقفة إحتجاجية وسط المدينة تبعتها مسيرة بشوارع المدينة ،تعبيرا عن استنكارهم

جرجيس : خلال زيارته الى الجهة رئيس الحكومة يطلع على مشاريع فضاء الانشطة الاقتصادية
في اطار زيارته الى ولاية مدنين و التي انطلقت منذ يوم امس تحول رئيس الحكومة هشام المشيشي اليوم الى مدينة جرجيس اين

جرجيس : خلال زيارته للجهة رئيس الحكومة يطلع على عدد من المشاريع
في اطار زيارته الى ولاية مدنين و التي انطلقت منذ يوم امس تحول رئيس الحكومة هشام المشيشي اليوم الى

المشيشي : ” ما حصل في جربة مجرّد سوء تفاهم “
أكّد رئيس الحكومة هشام المشيشي اليوم على هامش زيارته إلى مدينة بن قردان أن مطالب أهالي جربة وبن قردان

قابس : وفاة شخص وإصابة 22 اخرين بكورونا
أفاد منسق خلية اليقظة الصحية بالإدارة الجهوية للصحة بقابس، حسين جبران، بأنه تم خلال الأربع والعشرين ساعة الماضية تسجيل

بعد رد فعل المشيشي على سؤال ملف جربة ولاية : تنسيقية جربة الولاية تقرر التحرك
قرر أعضاء تنسيقية جربة ولاية في ساعة متأخرة من ليلة البارحة وبصفة استعجالية عقد ندوة صحفية على الساعة العاشرة

شركة البيئة و الغراسات بتطاوين : الاٍنطلاق في عملية فرز ملفات المترشحين بداية من الاٍثنين القادم
أكدت إدارة شركة البيئة و الغراسات بتطاوين أنه في إطار تنفيذ قرارات رئيس الحكومة و المتعلقة بملف التنمية والتشغيل

اٍنتشال جثتين مجهولتي الهوية بسواحل جرجيس و بنقردان
تمكنت وحدات الحرس البحري بجرجيس و الحماية المدنية بكل من جرجيس و بنقردان من انتشال جثتين مجهولتي الهوية الأولى
المدير الجهوي للصحة بالقصرين : إصابة 6 أشخاص أصيلي مدينة سبيطلة ومنطقة الرحيات بالسلالة البريطانية لكورونا
أكد المدير الجهوي للصحة بالقصرين الدكتور عبد الغني الشعباني أن مخبر مستشفى شارل نيكول قام بتحليل عينات لمصابين بفيروس

